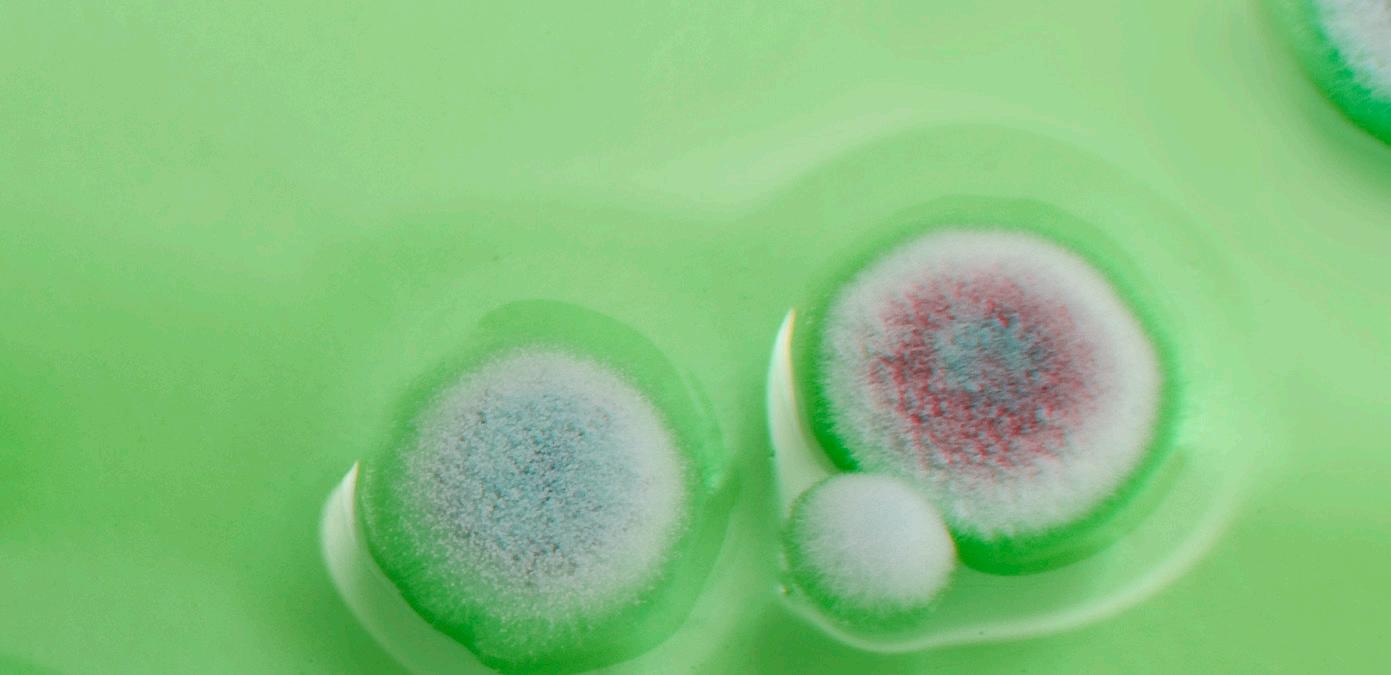

BIODETECT SYSTEM UND PRO-CLEAN
Qualitätsprüfung von Oberflächen vor und nach der Sanierung von Schimmelpilz- und Bakterienschäden




SCHNELL PRÄZISION EINFACHE ANWENDUNG




![]()
Qualitätsprüfung von Oberflächen vor und nach der Sanierung von Schimmelpilz- und Bakterienschäden




SCHNELL PRÄZISION EINFACHE ANWENDUNG




Wir von NAC Europe möchten diese Gelegenheit nutzen, uns für Ihr Interesse an unserem Unternehmen und unseren Produkten zu bedanken. Wir glauben, das BioDetect System könnte ein wichtiges Werkzeug für Ihr Unternehmen in Verbindung mit der Schimmelsanierung sowie der Reinigung und Desinfektion nach Feucht- und Wasserschäden werden. Das Produkt ermöglicht es Ihnen, die Qualität der ausgeführten Arbeiten auf der Stelle zu kontrollieren - ein Faktor, der sehr wichtig ist, wenn Sie und Ihr Unternehmen beschädigte Gebäude und Baumaterialien wieder auf ihren ursprünglichen Zustand bringen soll, d.h. frei von schädlichen Schimmelpilzen und anderen Mikroorganismen.
Das BioDetect System verwendet eine patentierte, biochemische Technologie, um genaue und zuverlässige Ergebnisse zu erhalten, die dem Benutzer die Möglichkeit geben, den Umfang der biologischen Verunreinigung auf Oberflächen innerhalb von 15 Sekunden zu bestimmen und das zu einem deutlich niedrigeren Preis als andere Methoden zur Probeentnahme.
Wir sind auch davon überzeugt, daß Ihre Fähigkeit, Zeit und Geld bei der Schadensanierung zu sparen, in hohem Maße Ihre Wettbewerbsfähigkeit am Markt steigern wird. Das BioDetect System gibt Ihnen einen Wettbewerbsvorteil und verbessert Ihre Möglichkeiten, Ihre Kunden in Verbindung mit Schimmelsanierungen usw. zu helfen.
Sollten Sie weitere Informationen ĂĽber das BioDetect System wĂĽnschen oder haben Sie technische Fragen, stehen wir gerne zu Ihrer VerfĂĽgung. Sie erreichen uns unter der Telefonnummer +45 74 42 62 92. Sehen Sie auch unsere Homepage www.nac-europe.com.
Mit freundlichen GrĂĽssen NAC EUROPE
Jesper Natorp
Nahaufnahme von Biofilm auf einer Oberfläche









DAS ZUKĂśNFTIGE SYSTEM ZUR SCHNELLEN MESSUNG
VON BIOVERUNREINIGUNG BEI SCHIMMEL- UND WASSERSCHÄDEN, USW.
SCHNELLES SYSTEM ZUR MESSUNG VON BIOVERUNREINIGUNG
Das BioDetect System hilft den Dienstleistern der Schaden- und Schimmelsanierung, Beratungsunternehmen im Bauwesen (Bauanalysen von u.a. Schimmelbefall), Versicherungsgesellschaften usw. schnell, genau und kostengünstig den Schimmel- und Bakterienbefall auf wassergeschädigte Materialien zu untersuchen. Der Biofilm, der in Zusammenhang mit Schimmel- und Bakterienwachstum auf wassergeschädigte Baumaterialien entsteht, kann mit Hilfe vom BioDetect System leicht detektiert werden.
Die Hauptfunktion des BioDetect Systems besteht darin, den Grad der Verschmutzung an Baumaterialien zu bestimmen und den Reinigungs- und Desinfektionseffekt nach einer Schimmel- oder Wasser-/Abwasserschadensanierung zu dokumentieren.
Wasserschäden und Schimmelbefall in Gebäuden und Wohnbereichen stellen ein schwerwiegendes Gesundheitsrisiko dar. Verunreinigte oder wassergeschädigte Baumaterialien und Flächen in Gebäuden können Innenluftprobleme verursachen, die sehr schwer zu identifizieren und zu behandeln sein können. Oft sind die Kosten in Verbindung mit Tests, das Einsammeln von Schimmelproben und die Schimmelsanierung an sich sehr hoch.
SCHNELL
EINFACHE ANWENDUNG
Ergebnis liegt innerhalb von 15 Sekunden vor PRÄZISION
+ / - 5% Abweichung
PREISGĂśNSTIG
Kostet nur einen Bruchteil von alternativen Methoden zur Probenahme
EINFACHE ANWENDUNG
Keine besondere Schulung erforderlich
LEICHT ABZULESEN
Einfache numerische Anzeige
EINFACH ZU VERWALTEN
Enthält Daten-Management-Software SCHNELL PRÄZISION
QUALITÄTSPRÜFUNG VON OBERFLÄCHEN VOR UND NACH DER SANIERUNG VON SCHIMMELPILZ- UND BAKTERIENSCHÄDEN - VERFAHREN ZUR ATP-PRÜFUNG VON OBERFLÄCHEN AUF SCHIMMEL UND BAKTERIEN
BioDetect Ultra Snap ATP Wattestäbchen und das BioDetect System Sure II Luminometer werden verwendet, um die Menge von lebensfähigen biologischen Materialien (Schimmel und Bakterien), Biofilm und anderen Mikroorganismen auf verunreinigten Oberflächen zu bestimmen. Der Zweck der Probenahme ist es, den Grad der biologischen Oberflächenverunreinigung auf gereinigten Substrate, Gebäudeoberflächen und Materialien, die Teil eines Sanierungsprojekts sind, sowie auf gereinigten und desinfizierten Baumaterialien zu bestimmen. Die Liste von Baumaterialien, die für die Probenahme mit BioDetect System geeignet sind, umfasst - ist aber nicht beschränkt auf - Wandpfosten

(Metall oder Holz), Beton-, Vinyl- und Keramikfliesen, Laminatoberflächen, Edelstahl, Mauerwerk, Plastik, Gipskarton, Holzplatten, Glas, u.a.m.
Das BioDetect System zur Detektierung von Bio-Verunreinigung ist entwickelt worden, um den Grad der Sauberkeit von Oberflächen und die Effizienz der Desinfektion in Verbindung mit der Schimmel- und Bakteriensanierung zu testen. Das System kann nicht erkennen, um welche Bakterien, Viren oder Pilzorganismen es sich handelt, sondern wird die Oberflächen definieren, wo diese Mikroorganismen als Folge von verschmutzten oder unhygienischen Bedingungen existieren können.





1. Wählen Sie, welche Oberfläche geprüft werden soll (zum Beispiel Wandpfosten (Metall oder Holz), Beton, Vinyl und Keramikfliesen, Laminatoberflächen, Edelstahl, Mauerwerk, Plastik, Gipskarton, Gipswände, Holzplatten, Glas, u.a.m.)
2. Benutzen Sie aseptische Techniken für alle Probeentnahmen. Den ATP Wattetupfer aus dem Rohr ziehen. Hierdurch wird der Tupfer, der befeuchtet ist um bei der Probenentnahme Biofilm einzusammeln, freigelegt. Es ist wichtig, dass die Tupfer nicht direkt mit den Fingern oder den Händen in Berührung kommen, da sie sonst verunreinigt werden.
3. Eine Fläche von ca. 10 x 10 cm von dem ausgewählten Areal mit ca. 10 vertikalen und 10 horizontalen Strichen abtupfen während der Tupfer über die Oberfläche gedreht wird. Der Wattetupfer kann auch zur Untersuchung von schwer zugänglichen Oberflächen benutzt werden, die entweder kleiner oder größer als 10 x 10 cm sind.
4. Nach dem Abtupfen wird der Wattetupfer wieder im Rohr eingefĂĽhrt.
5. Hart um die Spitze des Tupfers klemmen und den kleinen, blauen Kunststoffstiel knicken. Halten Sie das Gerät während dieses Vorgangs aufrecht.
6. DrĂĽcken Sie die Spitze zweimal um die FlĂĽssigkeit in der Kammer freizugeben. Die FlĂĽssigkeit wird dann in das Plastikrohr zurĂĽckflieĂźen.
7. Die Einheit gut schĂĽtteln um die FlĂĽssigkeiten zu vermischen (5 Sekunden). Dadurch wird sichergestellt, dass der Wattetupfer mit der FlĂĽssigkeit in Kontakt kommt.
8. Öffnen Sie den Deckel vom System Sure II Luminometer und führen Sie die gesamte Einheit von oben in das Gerät ein. Die Einheit muss ganz in die Öffnung eingeführt werden, bevor der Deckel vom Luminometer geschlossen wird. Um ein möglichst genaues Ergebnis zu erhalten, wird die Prüfeinheit in das Luminometer eingesetzt und innerhalb von 60 Sekunden nachdem der Stiel geknickt wurde und die Flüssigkeit aktiviert worden ist (Schritt 5) abgelesen.
9. SchlieĂźen Sie den Deckel des Luminometers.
10. Drücken Sie die “OK” Taste, um das Testergebnis abzulesen. Dieser Vorgang dauert 15 Sekunden ab der Aktivierung der “OK” Taste. Um ein möglichst genaues Ergebnis zu erhalten, soll das Instrument Senkrecht gehalten werden.

Einfache und leichte Anwendung - nur abtupfen, knicken, drĂĽcken und ablesen

BIO DETECT FĂśR IICRC S520 ANALYSE
Die getesteten Oberflächen waren relativ trocken oder waren mit Wasser in Berührung und waren fast trocken, als sie auf ATP getestet wurden.
Zustand der getesteten Oberfläche
NORMALE PILZ Ă–KOLOGIE
(Innenräume, wo kolonisierte Sporen, Pilzfragmente oder Spuren von Wachstum vorkommen können, de-ren Identität, Platzierung und Menge einer normalen Pilz Ökologie in ähnlichen Umgebungen widerspiegelt)
KOLONISIERTE SPOREN
(Innenräume, die vor allem von kolonisierten Sporen angegriffen sind, die entweder direkt oder indirekt von einem Zustand 3 Bereich verbreitet sind, und die Anzeichen eines realen Wachstums zeigen)
REALES WACHSTUM
(Innenräume, die tatsächlich von Schimmel und Schimmelsporen angegriffen sind. Reales Wachstum umfasst Wachstum, das aktiv oder inaktiv, sichtbar oder unsichtbar ist)
1 Genehmigt 2 Vorsicht
3 Nicht genehmigt
* ATP Ergebnisse die auf Zustand 1 Bezug nahmen, hingen von der allgemeinen Qualität der Reinigung auf die getesteten Bereiche oder Flächen zusammen. Typische Zustand 1 Oberflächen lösten ATP Ergebnisse im Bereich von 1 RLU bis 50 RLU aus. Manche Proben lagen allerdings auf bis zu 150 RLU.





DETECT
Die getesteten Oberflächen waren relativ feucht oder enthielten aktiv eindringende Feuchtigkeit in Form von Wasser, als sie von ATP getestet wurden.
Zustand der getesteten Oberfläche
NORMALE PILZ Ă–KOLOGIE
(Innenräume, wo kolonisierte Sporen, Pilzfragmente oder Spuren von Wachstum vorkommen können, de-ren Identität, Platzierung und Menge einer normalen Pilz Ökologie in ähnlichen Umgebungen widerspiegelt)
KOLONISIERTE SPOREN
(Innenräume, die vor allem von kolonisierten Sporen angegriffen sind, die entweder direkt oder indirekt von einem Zustand 3 Bereich verbreitet sind, und die Anzeichen eines realen Wachstums zeigen)
REALES WACHSTUM
(Innenräume, die tatsächlich von Schimmel und Schimmelsporen angegriffen sind. Reales Wachstum umfasst Wachstum, das aktiv oder inaktiv, sichtbar oder unsichtbar ist)
Vorsicht 3 Nicht genehmigt
* ATP Ergebnisse die auf Zustand 1 Bezug nahmen, hingen von der allgemeinen Qualität der Reinigung auf die getesteten Bereiche oder Flächen zusammen. Typische Zustand 1 Oberflächen lösten ATP Ergebnisse im Bereich von 1 RLU bis 50 RLU aus. Manche Proben lagen allerdings auf bis zu 150 RLU.
a) Beschädigte Probetupfer oder Probetupfer, die irrtümlich aktiviert wurden, sollten nicht verwendet sondern zerstört werden.
b) Die verwendeten Probetupfer können als Hausmüll entsorgt werden. Es gibt keine besonderen Vorsichtsmaßnahmen.
c) Vermeiden Sie das Einsammeln größerer Mengen von Probematerial an den Tupfer. Zu große Mengen von Material kann die Signalstärke beim Test reduzieren und ungenaue Ergebnisse zur Folge haben.
d) Während Pkt. 10 BioDetect Systemsure II senkrecht halten.
e) Halten Sie den BioDetect Ultrasnap ATP Wattetupfer senkrecht, während dieser aktiviert und geschüttelt wird (Pkt. 5)
f) Die BioDetect Ultra Snap ATP Wattetupfer vertragen Lagerung bei Raumtemperatur fĂĽr bis zu einem Monat, alle unbenutzte Testtupfer sollten jedoch im KĂĽhlschrank aufbewahrt werden, wo sie fĂĽr bis zu 12 Monate haltbar sind.
















BIODETECT - PRO-CLEAN TEST
PRO-Clean ist eine schnelle und einfache Methode zur genauen Bestimmung der Oberflächenreinheit zur Sicherung der Produktqualität. PRO-Clean enthüllt Proteinreste, die sich nach der Reinigung noch auf der Oberfläche befinden. Streichen Sie den Tupfer über die Oberfläche, geben Sie dann die Flüssigkeit frei und wenn Proteinrückstände vorhanden sind, färbt sich der Indikator Lila.
Der Farbwechsel gibt ein semi-quantitatives Bild von der Oberflächenreinheit. Je mehr Verunreinigung vorhanden ist, umso schneller wechselt die Farbe in Lila und je dunkler ist die Farbe. PRO-Clean validiert schnell das Hygieneniveau auf der Oberfläche und ermöglicht daher eine schnelle Reaktion, falls erforderlich.






